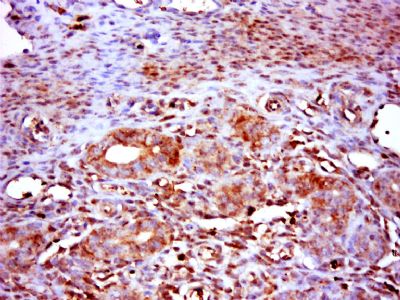
产品封面图

相关产品推荐更多 >
万千商家帮你免费找货
0 人在求购买到急需产品
- 详细信息
- 技术资料
- 供应商:
上海康朗生物科技有限公司
- 库存:
大量
- 目录编号:
kl-9225R
- 克隆性:
多克隆
- 抗原来源:
Rabbit
- 保质期:
12个月
- 抗体英文名:
RNF14 antibody
- 抗体名:
环指蛋白14抗体
- 宿主:
Rabbit
- 适应物种:
Human, Mouse, Rat, Dog, Pig, Cow, Rabbit, Sheep,
- 免疫原:
KLH conjugated synthetic peptide derived from human RNF14:71-170/474
- 亚型:
IgG
- 形态:
冻干粉或液体
- 应用范围:
WB=1:500-2000 ELISA=1:500-1000 IHC-P=1:400-800 IHC-F=1:400-800 IF=1:50-200
- 浓度:
1mg/ml
- 保存条件:
-20 °C
- 规格:
100ul 200ul
RNF14 antibody
| 中文名称 | 环指蛋白14抗体 |
| 别 名 | Androgen receptor associated protein 54; Androgen receptor-associated protein 54; ARA 54; ARA54; E3 ubiquitin protein ligase RNF14; E3 ubiquitin-protein ligase RNF14; FLJ26004; HFB 30; HFB30; HRIHFB2038; RING finger protein 14; RNF 14; Rnf14; RNF14_HUMAN; TRIAD 2; TRIAD2; Triad2 protein. |
| 规格价格 | 100ul/1380元 购买 200ul/2200元 购买 大包装/询价 |
| 说 明 书 | 100ul 200ul |
| 研究领域 | 细胞生物 信号转导 表观遗传学 |
| 抗体来源 | Rabbit |
| 克隆类型 | Polyclonal |
| 交叉反应 | Human, Mouse, Rat, Dog, Pig, Cow, Rabbit, Sheep, |
| 产品应用 | WB=1:500-2000 ELISA=1:500-1000 IHC-P=1:400-800 IHC-F=1:400-800 IF=1:50-200 (石蜡切片需做抗原修复) not yet tested in other applications. optimal dilutions/concentrations should be determined by the end user. |
| 分 子 量 | 54kDa |
| 细胞定位 | 细胞核 细胞浆 |
| 性 状 | Lyophilized or Liquid |
| 浓 度 | 1mg/ml |
| 免 疫 原 | KLH conjugated synthetic peptide derived from human RNF14:71-170/474 |
| 亚 型 | IgG |
| 纯化方法 | affinity purified by Protein A |
| 储 存 液 | 0.01M TBS(pH7.4) with 1% BSA, 0.03% Proclin300 and 50% Glycerol. |
| 保存条件 | Store at -20 °C for one year. Avoid repeated freeze/thaw cycles. The lyophilized antibody is stable at room temperature for at least one month and for greater than a year when kept at -20°C. When reconstituted in sterile pH 7.4 0.01M PBS or diluent of antibody the antibody is stable for at least two weeks at 2-4 °C. |
| PubMed | PubMed |
| 产品介绍 | background: Might act as an E3 ubiquitin-protein ligase which accepts ubiquitin from specific E2 ubiquitin-conjugating enzymes and then transfers it to substrates, which could be nuclear proteins. Could play a role as a coactivator for androgen- and, to a lesser extent, progesterone-dependent transcription. Function: Might act as an E3 ubiquitin-protein ligase which accepts ubiquitin from specific E2 ubiquitin-conjugating enzymes and then transfers it to substrates, which could be nuclear proteins. Could play a role as a coactivator for androgen- and, to a lesser extent, progesterone-dependent transcription. Subunit: Interacts with the ubiquitin-conjugating enzymes UBE2E1 and UBE2E2. Interacts with AR/androgen receptor; testosterone- and RNF6-regulated it promotes AR transcriptional activity. Subcellular Location: Cytoplasm. Nucleus. Tissue Specificity: Widely expressed. Post-translational modifications: RING-type zinc finger-dependent and UBE2E2-dependent autoubiquitination. [SIMILARITY] Similarity: Belongs to the RBR family. RNF14 subfamily. Contains 1 IBR-type zinc finger. Contains 2 RING-type zinc fingers. Contains 1 RWD domain. SWISS: Q9UBS8 Gene ID: 9604 Database links: Entrez Gene: 9604 Human Entrez Gene: 56736 Mouse Entrez Gene: 619577 Rat Omim: 605675 Human SwissProt: Q9UBS8 Human SwissProt: Q9JI90 Mouse Unigene: 483616 Human Unigene: 228903 Mouse Unigene: 115357 Rat Important Note: This product as supplied is intended for research use only, not for use in human, therapeutic or diagnostic applications. |
| 产品图片 | ![]() Sample: Cerebellum (Mouse) Lysate at 40 ug Primary: Anti-RNF14 (bs-9225R) at 1/300 dilution Secondary: IRDye800CW Goat Anti-Rabbit IgG at 1/20000 dilution Predicted band size: 54 kD Observed band size: 50 kD ![]() Sample: Placenta (Mouse) Lysate at 40 ug Primary: Anti-RNF14 (bs-9225R) at 1/300 dilution Secondary: IRDye800CW Goat Anti-Rabbit IgG at 1/20000 dilution Predicted band size: 54 kD Observed band size: 50 kD ![]() Paraformaldehyde-fixed, paraffin embedded (rat uterus); Antigen retrieval by boiling in sodium citrate buffer (pH6.0) for 15min; Block endogenous peroxidase by 3% hydrogen peroxide for 20 minutes; Blocking buffer (normal goat serum) at 37°C for 30min; Antibody incubation with (FAM160B1) Polyclonal Antibody, Unconjugated (bs-9225R) at 1:500 overnight at 4°C, followed by a conjugated secondary (sp-0023) for 20 minutes and DAB staining. |
风险提示:丁香通仅作为第三方平台,为商家信息发布提供平台空间。用户咨询产品时请注意保护个人信息及财产安全,合理判断,谨慎选购商品,商家和用户对交易行为负责。对于医疗器械类产品,请先查证核实企业经营资质和医疗器械产品注册证情况。
技术资料暂无技术资料 索取技术资料
RNF14 antibody
¥1380 - 2200